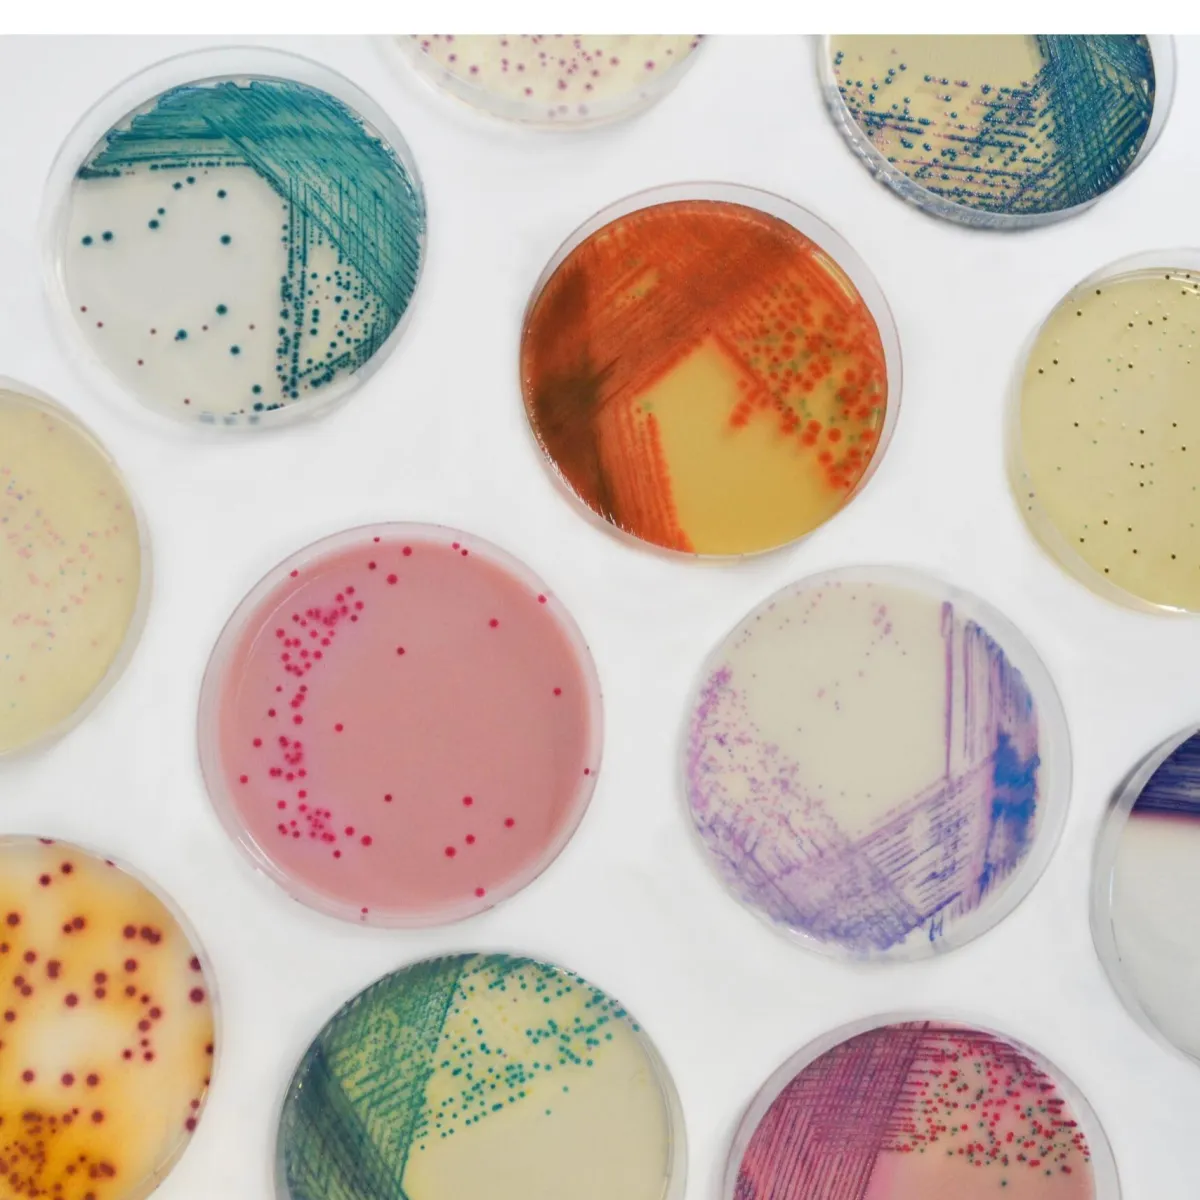
Chromogenic Culture Medias

Chromogenic Culture Medias
Culture Media
Information
Chromogenic technology is a powerful tool for detecting targeted microorganisms even in mixed culture conditions, allowing the user to:
- Phenotypic detection, i.e. on the basis of the pattern actually expressed by the microorganism,
- Facilitate the final identification (no subculture, fewer colonies to test),
- A faster and more efficient result.
